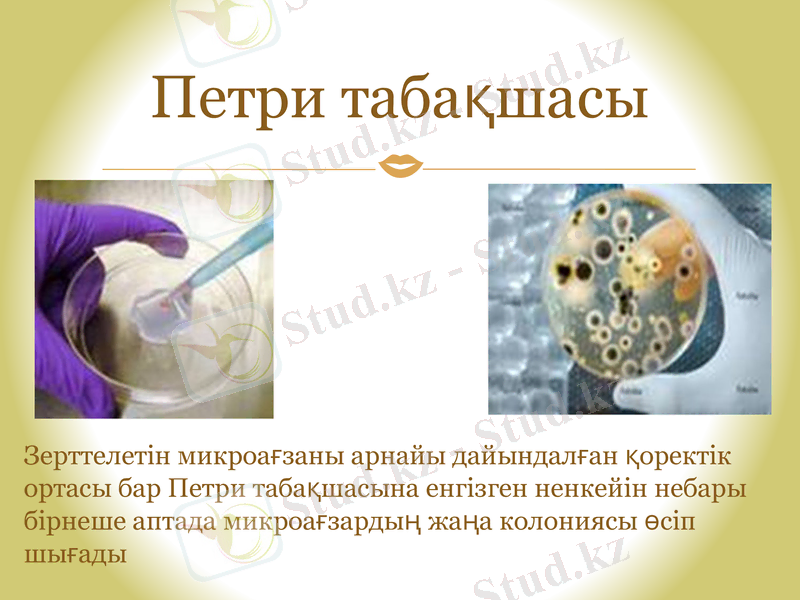
Slide 11

Тағам өнеркәсібіндегі микроорганизмдер: биотехнологиялық принциптер мен қолданбалы технологиялар



Тағам өнеркәсібінде қолданылатын микроорганизмдер
Орындаған:Билалова А. Н
Тексерген:Кабденова А. Т



Биотехнология
Биотехнология - бұл микроорганизмдердің тіршілік ету қабілетін, жасуша мен ұлпаның культураларын және оның бөлшектерін өндірісте қолдану мақсатының жетістігі және биохимия, микробиология және инженерлік ғылымдарды қолдануды интегрирлеу.

Тағам биотехнологиясы
Организм
Бастапқы өнім
Өнімділігі, г
Сиыр
1 кг. азықтық
68г. сиыр еті
Шошқа
1 кг. азықтық
200г. шошқа
Тауық
1кг. азықтық
240 г. тауық еті
Fusarium graminearum
1кг. көмірсу+неорганикалық Азот + О2
1080 жасушалық массалары
Биоконверсия шикізатының эффективтілігі



Микроорганизмдер биотехнологиясы
«Микроорганизмдер биотехнологиясы» пәнінің мақсаты болып микроорганизмдердің мүмкіндіктерімен танысып биомассаны бөліп алу, микроорганизмдерді пайдаланып биосинтез және биотрансформация өнімдерін алу, олардың технологиялық процестерін құрасатыру, өндірістің технологияларын қолданып биотехнологияның салаларының құрылысымен танысу, микроорганизмдерді пайдаланып ең маңызды өнімдерді биологиялық активтік заттарды бөліп алу, шикізат ретінде оңай табылатын өнімдерді қолданып, сапасы жоғары өнімдерді алуға арналған осы технологияларға, процесстерге қажет құрал-жабдықтардың құрылысын зерттеп, тереңірек меңгеру

Микроорганизмдердің ерекшеліктері:
1. Біркелкі таралады.
2. Тез өседі және көбейеді.
3. Басқа ағзаларға қарағанда төзімді(t=70-105С, радиация, NaCl=25-30%, кептіру, оттегінің жоқтығы, t=(-), және т. б. )
4. Қоректенуі :автотрофтар (фото- и хемо-), гетеротрофтар (барлық органикалық заттарды, қажет емес қосылыстарды, нитраттарды ыдыратады. күкіртті қосылыстар және басқа да улы заттар)

Сүт қышқылы бактериялары
1 - шар тәрізділер; 2 - моншақ тәрізді орналасқан стрептококкалар;
3 - таяқша тәрізділері.
Петри табақшасы
Зерттелетін микроағзаны арнайы дайындалған қоректік ортасы бар Петри табақшасына енгізген ненкейін небары бірнеше аптада микроағзардың жаңа колониясы өсіп шығады
- Іс жүргізу
- Автоматтандыру, Техника
- Алғашқы әскери дайындық
- Астрономия
- Ауыл шаруашылығы
- Банк ісі
- Бизнесті бағалау
- Биология
- Бухгалтерлік іс
- Валеология
- Ветеринария
- География
- Геология, Геофизика, Геодезия
- Дін
- Ет, сүт, шарап өнімдері
- Жалпы тарих
- Жер кадастрі, Жылжымайтын мүлік
- Журналистика
- Информатика
- Кеден ісі
- Маркетинг
- Математика, Геометрия
- Медицина
- Мемлекеттік басқару
- Менеджмент
- Мұнай, Газ
- Мұрағат ісі
- Мәдениеттану
- ОБЖ (Основы безопасности жизнедеятельности)
- Педагогика
- Полиграфия
- Психология
- Салық
- Саясаттану
- Сақтандыру
- Сертификаттау, стандарттау
- Социология, Демография
- Спорт
- Статистика
- Тілтану, Филология
- Тарихи тұлғалар
- Тау-кен ісі
- Транспорт
- Туризм
- Физика
- Философия
- Халықаралық қатынастар
- Химия
- Экология, Қоршаған ортаны қорғау
- Экономика
- Экономикалық география
- Электротехника
- Қазақстан тарихы
- Қаржы
- Құрылыс
- Құқық, Криминалистика
- Әдебиет
- Өнер, музыка
- Өнеркәсіп, Өндіріс
Қазақ тілінде жазылған рефераттар, курстық жұмыстар, дипломдық жұмыстар бойынша біздің қор #1 болып табылады.



Ақпарат
Қосымша
Email: info@stud.kz